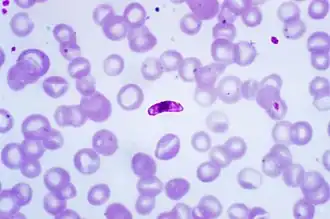

Parasitemia
| Parasitemia | ||
|---|---|---|
![]() Plasmodium falciparum en un frotis sanguíneo periférica evidenciando una parasitemia. | ||
| Especialidad | infectología | |
Parasitemia es la presencia de parásitos en el torrente circulatorio.[1] Entre los principales parásitos que provocan parasitemia se encuentran los microorganismos del género Plasmodium (causantes del paludismo)[1][2] y Tripanosoma (causantes de las tripanosomiasis).[3]
Las parasitemias causan la difusión del microorganismo en el cuerpo y en algunas enfermedades suelen ser diagnósticas o de tamizaje.[4][5]
Véase también
- Septicemia
- Paludismo
- Tripanosomiasis
- Tripanosomiasis americana (enfermedad de Chagas)
- Tripanosomiasis africana (enfermedad del sueño)
Referencias
- ↑ a b Término MeSH para parasitemia
- ↑ Kumate, Jesús; Gutiérrez, Gonzalo; Muñoz, Onofre; Santos, Ignacio; Solórzano Fontino; Miranda Guadalupe (2008). «Capítulo 69: Paludismo». Infectología Clínica Kumate-Gutiérrez (17.ª edición). México: Méndez Editores (publicado el 2009). pp. 717-730. ISBN 968-5328-77-3. OCLC 728653050.
- ↑ Kumate, Jesús; Gutiérrez, Gonzalo; Muñoz, Onofre; Santos, Ignacio; Solórzano Fontino; Miranda Guadalupe (2008). «Capítulo 71: Trypanosomosis Americana (Enfermedad de Chagas)». Infectología Clínica Kumate-Gutiérrez (17.ª edición). México: Méndez Editores (publicado el 2009). pp. 745-740. ISBN 968-5328-77-3. OCLC 728653050.
- ↑ Patrick R. Murray; Ken S. Rosenthal; Michael A. Pfaller (Abril de 2009). «Capítulo 6: Clasificación, estructura y replicación de los parásitos». En Patrick R. Murray, ed. Microbiología Médica (6.ª edición). España: Elsevier-Mosby. pp. 65-72. ISBN 978-84-8086-465-7. OCLC 733761359. Consultado el 31 de marzo de 2012.
- ↑ López Antuñano, Francisco Javier (Sep de 1997). «Quimioterapia de las infecciones producidas por Trypanosoma cruzi». Salud pública Méx 39 (5): 463-471. doi:10.1590/S0036-36341997000500009. Consultado el 9 de abril de 2012.
Enlaces externos
Wikimedia Commons alberga una galería multimedia sobre parásito.
Wikcionario tiene definiciones y otra información sobre parasitemia.